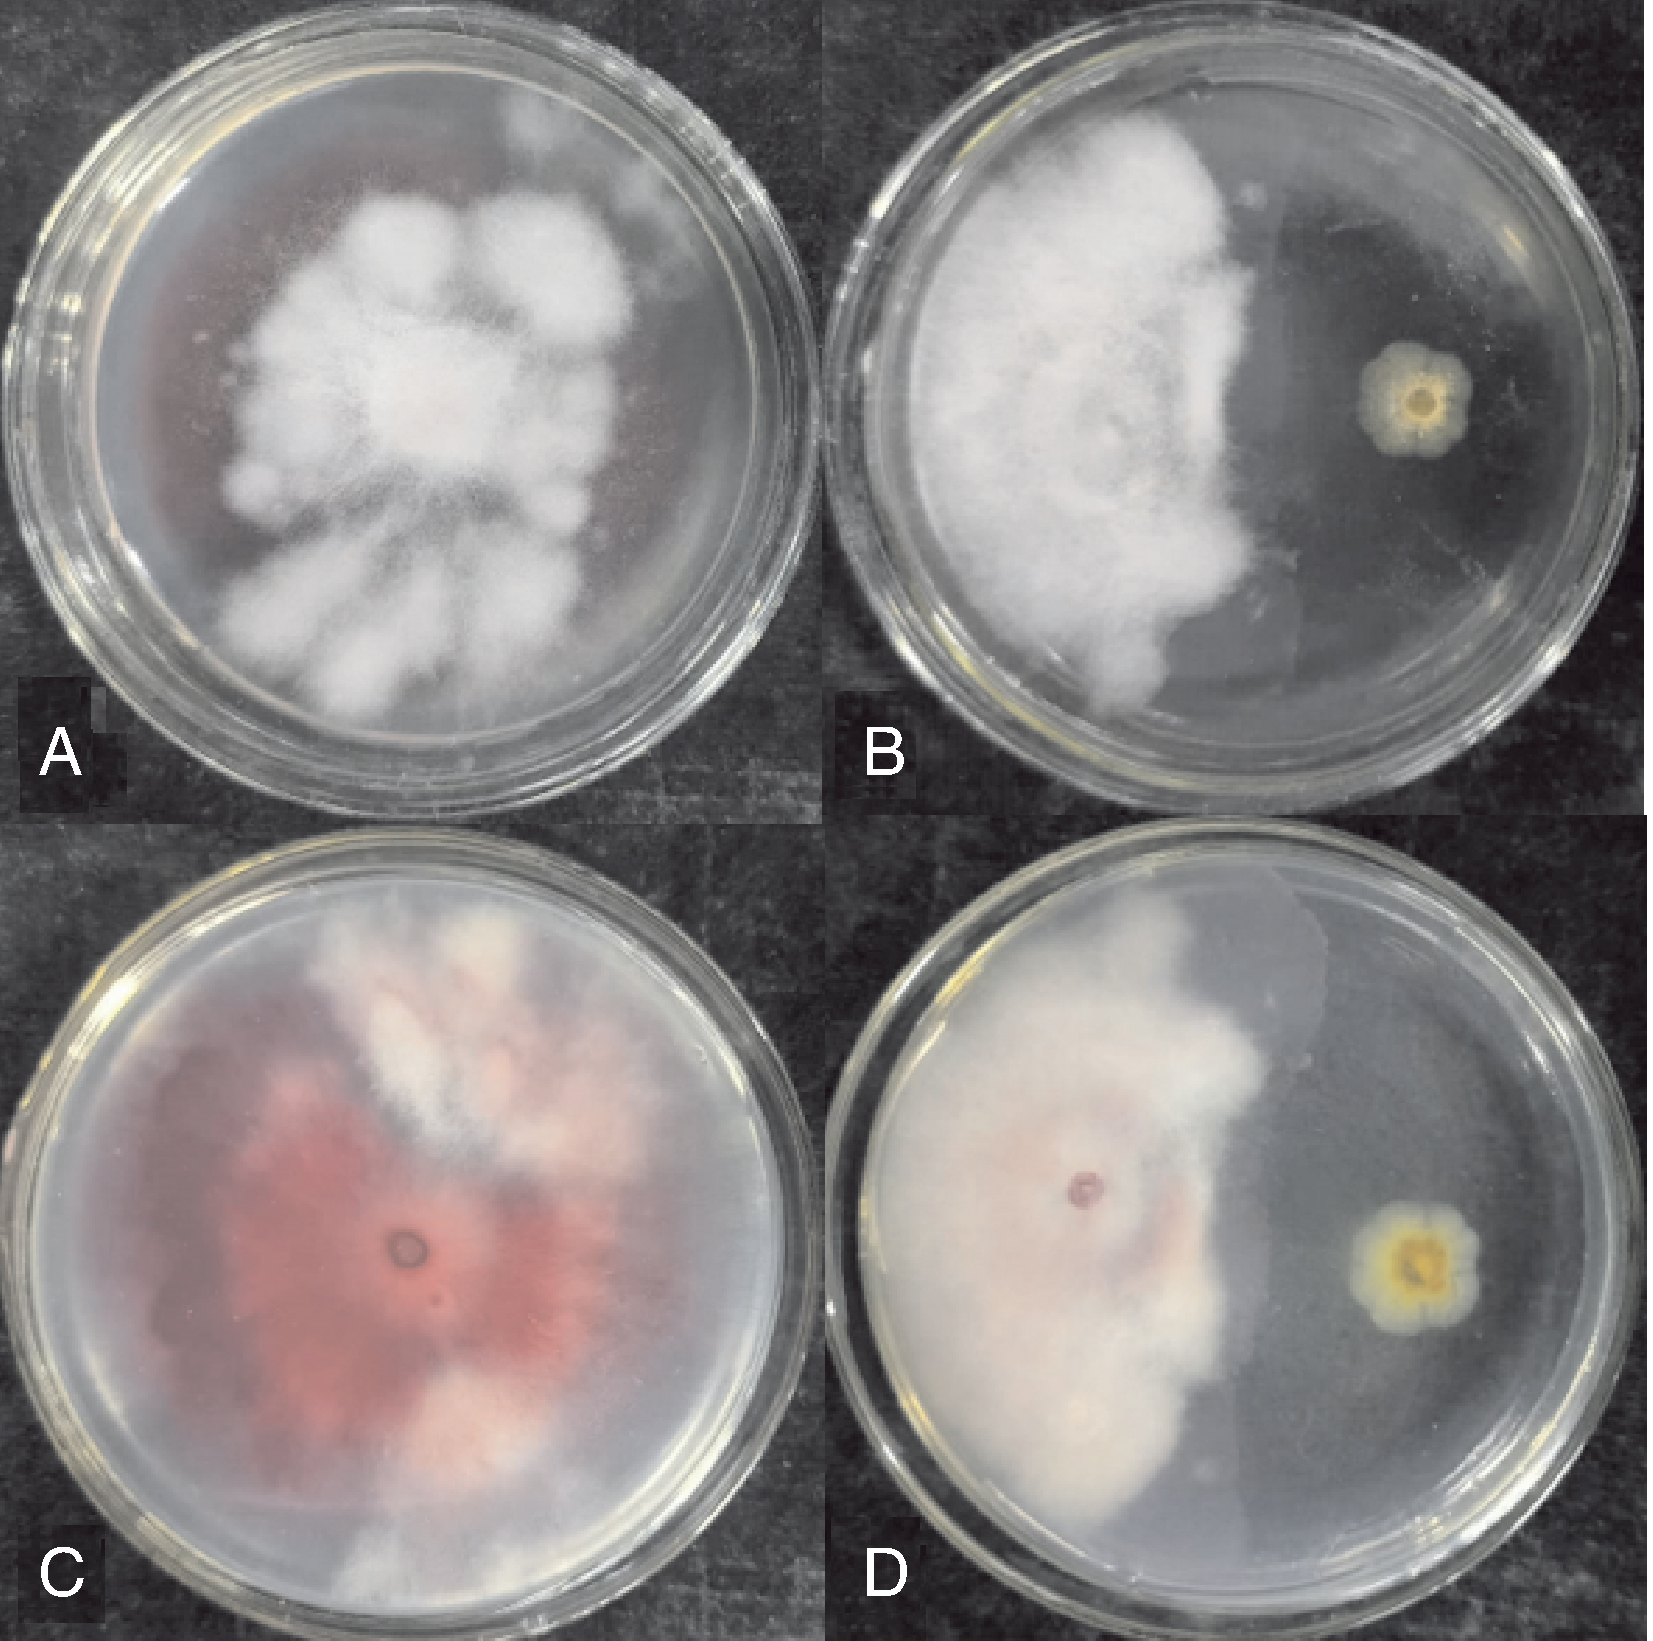
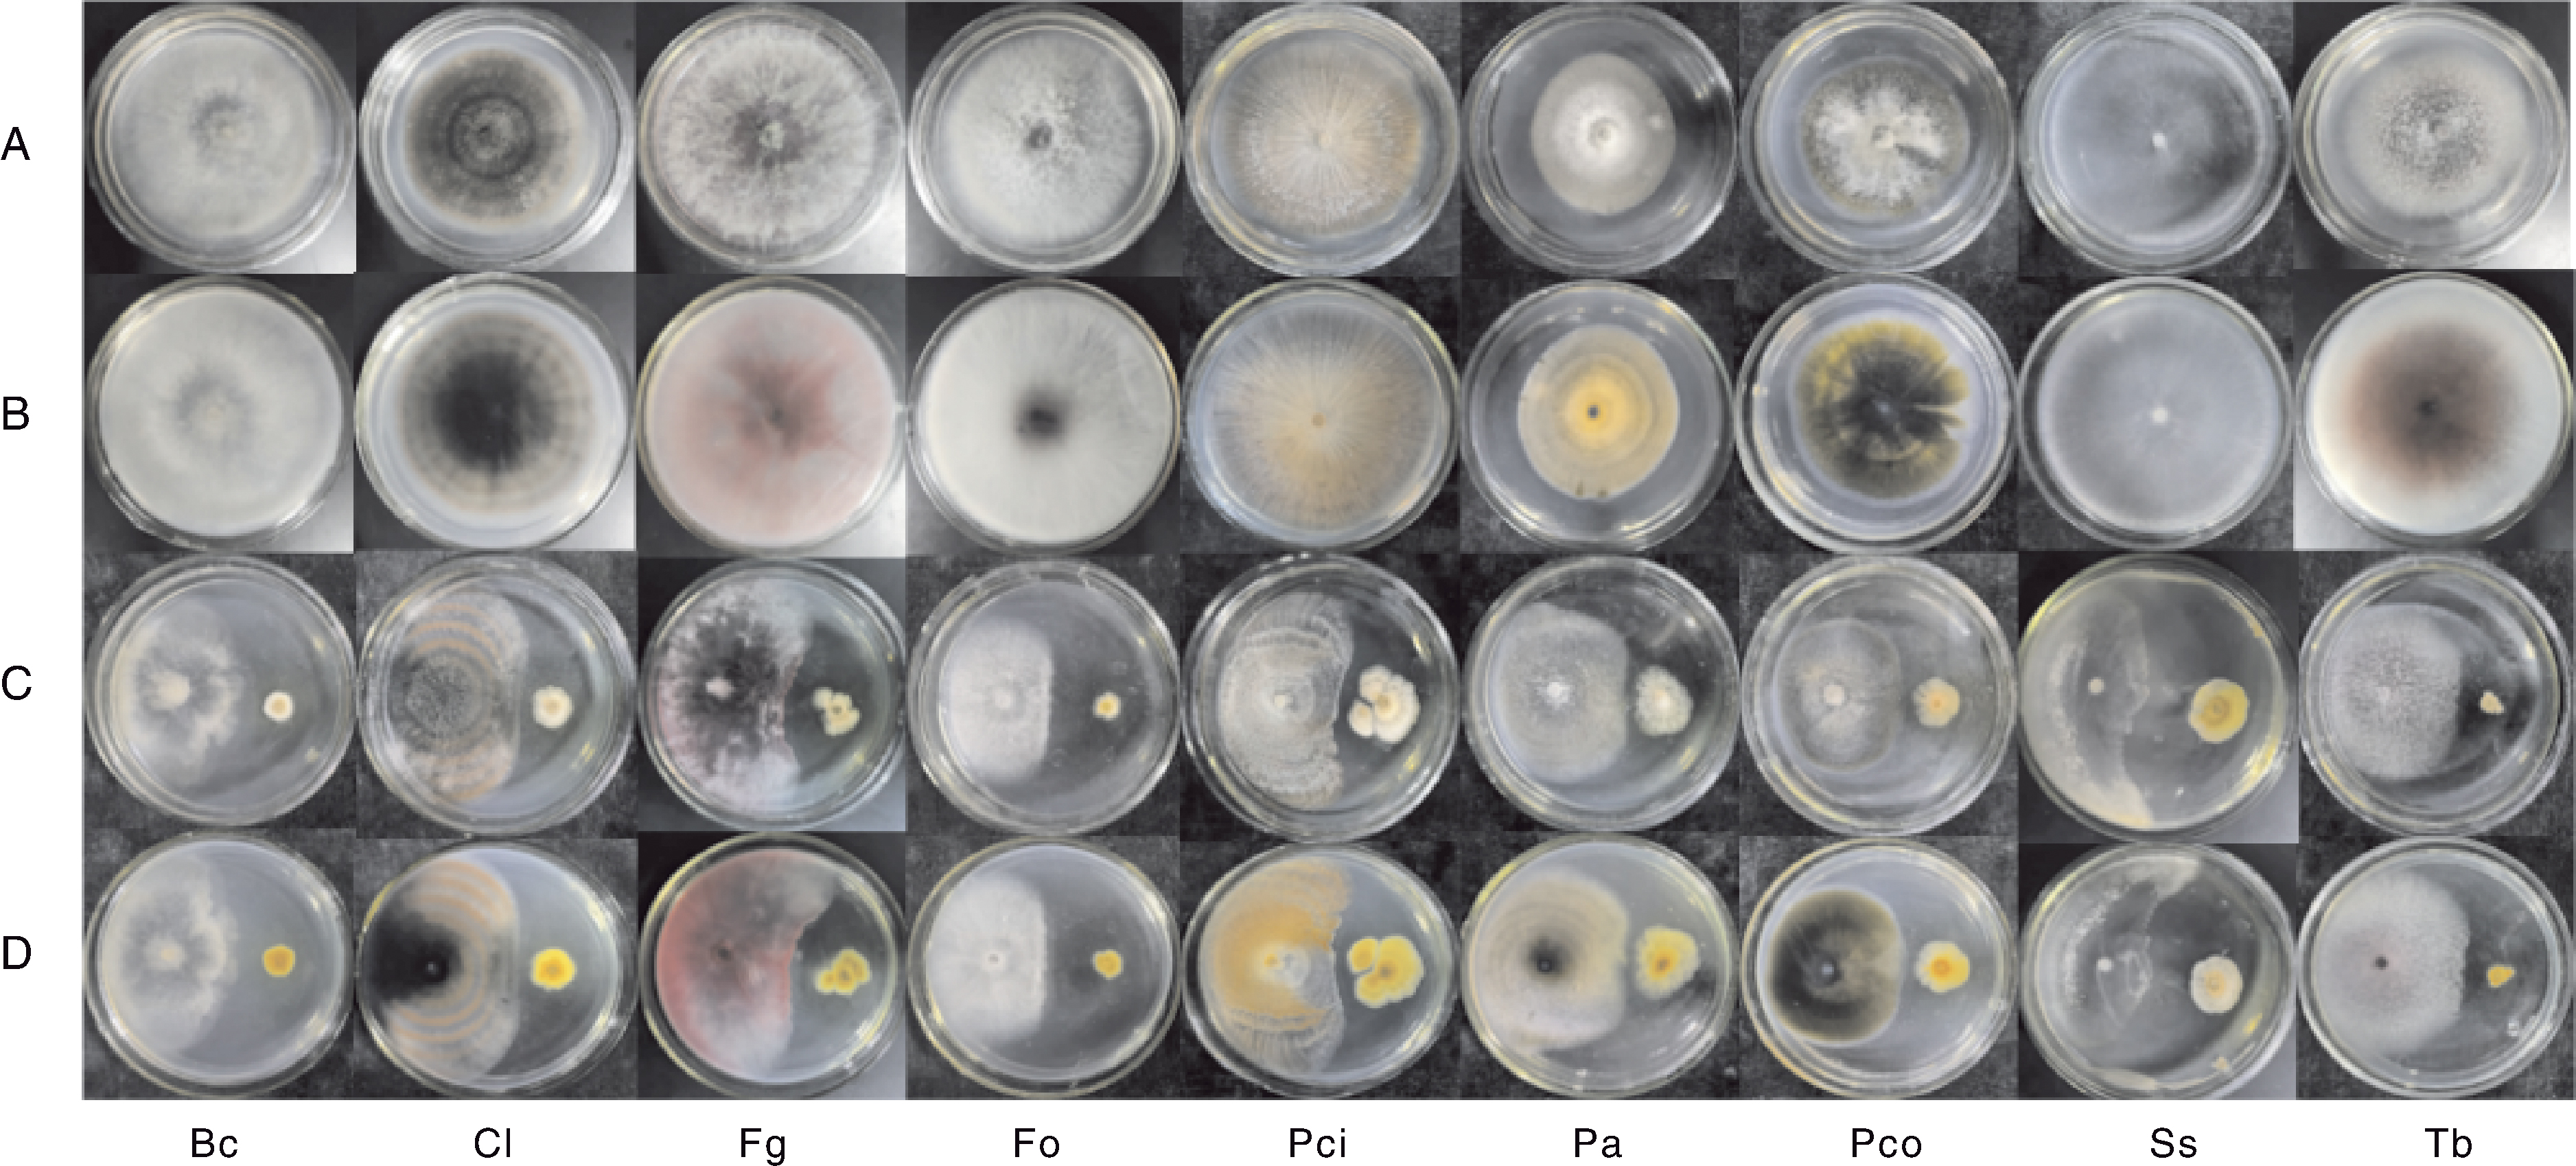

Acta Agriculturae Zhejiangensis ›› 2025, Vol. 37 ›› Issue (12): 2535-2544.DOI: 10.3969/j.issn.1004-1524.20241071
• Plant Protection • Previous Articles Next Articles
Isolation of rhizosphere fungi from wheat and their antifungal activity
SONG Yingjun( ), CAI Yihao, ZHANG Lixia, LYU Shufang, LI Wenwen, SUO Chenmei, ZHANG Hao, HOU Dianyun, ZHAO Xingli*(
), CAI Yihao, ZHANG Lixia, LYU Shufang, LI Wenwen, SUO Chenmei, ZHANG Hao, HOU Dianyun, ZHAO Xingli*( )
)
- College of Agriculture, Henan University of Science and Technology, Luoyang 471023, Henan, China
-
Received:2024-12-07Online:2025-12-25Published:2026-01-09
CLC Number:
Cite this article
SONG Yingjun, CAI Yihao, ZHANG Lixia, LYU Shufang, LI Wenwen, SUO Chenmei, ZHANG Hao, HOU Dianyun, ZHAO Xingli. Isolation of rhizosphere fungi from wheat and their antifungal activity[J]. Acta Agriculturae Zhejiangensis, 2025, 37(12): 2535-2544.
share this article
Add to citation manager EndNote|Ris|BibTeX
URL: http://www.zjnyxb.cn/EN/10.3969/j.issn.1004-1524.20241071
| 属 Genus | 菌株编号 Strain number | GenBank登录号 Accession number in GenBank | 最相关的菌株(登录号) Most closely related strain (accession number) | 一致性 Identity/% |
|---|---|---|---|---|
| 曲霉属Aspergillus | W-F-5 | PQ577766 | Aspergillus niger(MN429196) | 100.00 |
| 枝孢属Cladosporium | W-F-6 | PQ577767 | Cladosporium cladosporioides(OM237122) | 99.61 |
| 镰孢属Fusarium | W-F-4 | PQ577765 | Fusarium fujikuroi (MN871566) | 99.81 |
| 耙菌属Irpex | W-F-13 | PQ577768 | Irpex lacteus(MT085750) | 99.84 |
| 青霉属Penicillium | W-F-15 | PQ577769 | Penicillium janthinellum(KT779551) | 99.63 |
| 帚枝霉属Sarocladium | W-F-22 | PQ577771 | Sarocladium spinificis(MZ447507) | 99.82 |
Table 1 Summary of representative rhizosphere fungi in each genus according to ITS sequences
| 属 Genus | 菌株编号 Strain number | GenBank登录号 Accession number in GenBank | 最相关的菌株(登录号) Most closely related strain (accession number) | 一致性 Identity/% |
|---|---|---|---|---|
| 曲霉属Aspergillus | W-F-5 | PQ577766 | Aspergillus niger(MN429196) | 100.00 |
| 枝孢属Cladosporium | W-F-6 | PQ577767 | Cladosporium cladosporioides(OM237122) | 99.61 |
| 镰孢属Fusarium | W-F-4 | PQ577765 | Fusarium fujikuroi (MN871566) | 99.81 |
| 耙菌属Irpex | W-F-13 | PQ577768 | Irpex lacteus(MT085750) | 99.84 |
| 青霉属Penicillium | W-F-15 | PQ577769 | Penicillium janthinellum(KT779551) | 99.63 |
| 帚枝霉属Sarocladium | W-F-22 | PQ577771 | Sarocladium spinificis(MZ447507) | 99.82 |
Fig.3 Antagonistic effect of strain W-F-20 on the pathogen of wheat crown rot A, Front view of the control (CK); B, Front view of the treatment with strain W-F-20; C, Back view of the control (CK); D, Back view of the treatment with strain W-F-20.
Fig.4 Antibiosis of W-F-20 strain against nine plant pathogenic fungi Bc, Botrytis cinerea; Cl, Curvularia lunata; Fg, Fusarium graminearum; Fo, Fusarium oxysporum; Pci, Penicillium citrinum; Pa, Phoma arachidicola; Pco, Phyllosticta commonsii, Ss, Sclerotinia sclerotiorum; Tb, Thielaviopsis basicola. The same as below. A, Front view of the control (CK); B, Back view of the control (CK); C, Front view of the treatment with strain W-F-20; D, Back view of the treatment with strain W-F-20.

Fig.5 Inhibition width of W-F-20 strain against ten plant pathogenic fungi Fp, Fusarium pesudograminearum. Bars marked without the same letters indicate significant (p<0.05) difference within treatments. The same as below.
| [1] | SINHA A, SINGH L, RAWAT N. Current understanding of atypical resistance against fungal pathogens in wheat[J]. Current Opinion in Plant Biology, 2022, 68: 102247. |
| [2] | 栾冬冬, 贾吉玉, 王光州, 等. 中国小麦茎基腐病的发生现状及防治策略[J]. 麦类作物学报, 2022, 42(4): 512-520. |
| LUAN D D, JIA J Y, WANG G Z, et al. Occurrence status and control strategies of wheat crown rot in China[J]. Journal of Triticeae Crops, 2022, 42(4): 512-520. (in Chinese with English abstract) | |
| [3] | SAVARY S, WILLOCQUET L, PETHYBRIDGE S J, et al. The global burden of pathogens and pests on major food crops[J]. Nature Ecology & Evolution, 2019, 3(3): 430-439. |
| [4] | NIU B, WANG W X, YUAN Z B, et al. Microbial interactions within multiple-strain biological control agents impact soil-borne plant disease[J]. Frontiers in Microbiology, 2020, 11: 585404. |
| [5] | STENBERG J A, SUNDH I, BECHER P G, et al. When is it biological control?: a framework of definitions, mechanisms, and classifications[J]. Journal of Pest Science, 2021, 94(3): 665-676. |
| [6] | HUANG X F, CHAPARRO J M, REARDON K F, et al. Rhizosphere interactions: root exudates, microbes, and microbial communities[J]. Botany, 2014, 92(4): 267-275. |
| [7] | MEENA V S, MEENA S K, VERMA J P, et al. Plant beneficial rhizospheric microorganism (PBRM) strategies to improve nutrients use efficiency: a review[J]. Ecological Engineering, 2017, 107: 8-32. |
| [8] | 周益帆, 白寅霜, 岳童, 等. 植物根际促生菌促生特性研究进展[J]. 微生物学通报, 2023, 50(2): 644-666. |
| ZHOU Y F, BAI Y S, YUE T, et al. Research progress on the growth-promoting characteristics of plant growth-promoting rhizobacteria[J]. Microbiology China, 2023, 50(2): 644-666. (in Chinese with English abstract) | |
| [9] | LACAVA P T, BOGAS A C, DE PAULA NOGUEIRA CRUZ F. Plant growth promotion and biocontrol by endophytic and rhizospheric microorganisms from the tropics: a review and perspectives[J]. Frontiers in Sustainable Food Systems, 2022, 6: 796113. |
| [10] | 徐飞, 宋玉立, 周益林, 等. 2013—2016年河南省小麦茎基腐病的发生危害情况及特点[J]. 植物保护, 2016, 42(6): 126-132. |
| XU F, SONG Y L, ZHOU Y L, et al. Occurrence dynamics and characteristics of Fusariumroot and crown rot of wheat in Henan Province during 2013-2016[J]. Plant Protection, 2016, 42(6): 126-132. (in Chinese with English abstract) | |
| [11] | XU F, YANG G Q, WANG J M, et al. Spatial distribution of root and crown rot fungi associated with winter wheat in the North China Plain and its relationship with climate variables[J]. Frontiers in Microbiology, 2018, 9: 1054. |
| [12] | KANG R J, LI G N, ZHANG M J, et al. Expression of Fusarium pseudograminearum FpNPS9 in wheat plant and its function in pathogenicity[J]. Current Genetics, 2020, 66(1): 229-243. |
| [13] | 赵静雅, 彭梦雅, 张时雨, 等. C2H2锌指转录因子FpCzf7参与假禾谷镰孢的生长和致病性[J]. 生物技术通报, 2022, 38(8): 216-224. |
| ZHAO J Y, PENG M Y, ZHANG S Y, et al. Role of C2H2 zinc finger transcription factor FpCzf7 in the growth and pathogenicity of Fusarium pseudograminearum[J]. Biotechnology Bulletin, 2022, 38(8): 216-224. (in Chinese with English abstract) | |
| [14] | 赵静雅, 夏荟清, 彭梦雅, 等. 假禾谷镰孢转录因子FpAPSES的鉴定与功能分析[J]. 中国农业科学, 2021, 54(16): 3428-3439. |
| ZHAO J Y, XIA H Q, PENG M Y, et al. Identification and functional analysis of transcription factors FpAPSES in Fusarium pseudograminearum[J]. Scientia Agricultura Sinica, 2021, 54(16): 3428-3439. (in Chinese with English abstract) | |
| [15] | 李怡文, 李桂香, 黄中乔, 等. 假禾谷镰孢引起的小麦茎基腐病发生危害与防控研究进展[J]. 农药学学报, 2022, 24(5): 949-961. |
| LI Y W, LI G X, HUANG Z Q, et al. Research progress on the occurrence, damage and prevention of Fusarium crown rot caused by Fusarium pseudograminearum[J]. Chinese Journal of Pesticide Science, 2022, 24(5): 949-961. (in Chinese with English abstract) | |
| [16] | 田秀, 黄路婷, 谢元贵, 等. 米槁果实不同发育时期根际土壤可培养真菌的动态变化[J]. 西南农业学报, 2022, 35(8): 1848-1854. |
| TIAN X, HUANG L T, XIE Y G, et al. Dynamic changes of cultivable fungi in rhizosphere soil during different developmental stages of Cinnamomum migao H. W. Li fruit[J]. Southwest China Journal of Agricultural Sciences, 2022, 35(8): 1848-1854. (in Chinese with English abstract) | |
| [17] | 方中达. 植病研究方法[M]. 北京: 中国农业出版社, 2007. |
| [18] | 魏景超. 真菌鉴定手册[M]. 上海: 上海科技出版社, 1979. |
| [19] | ZHAO X L, HU Z J, HOU D Y, et al. Biodiversity and antifungal potential of endophytic fungi from the medicinal plant Cornus officinalis[J]. Symbiosis, 2020, 81(3): 223-233. |
| [20] | ZHAO X L, SONG P, HOU D Y, et al. Antifungal activity, identification and biosynthetic potential analysis of fungi against Rhizoctonia cerealis[J]. Annals of Microbiology, 2021, 71(1): 41. |
| [21] | CAMARGO J A. Can dominance influence stability in competitive interactions?[J]. Oikos, 1992, 64(3) : 605-609. |
| [22] | KUSARI P, KUSARI S, SPITELLER M, et al. Endophytic fungi harbored in Cannabis sativa L. diversity and potential as biocontrol agents against host plant-specific phytopathogens[J]. Fungal Diversity, 2013, 60(1): 137-151. |
| [23] | 贾南豫, 朱水英, 蒋栋, 等. 施用液体有机肥对干旱胁迫下玉米和小麦生长及根际微生物的影响[J]. 南京农业大学学报, 2024, 48(5): 1060-1069. |
| JIA N Y, ZHU S Y, JIANG D, et al. The effect of liquid organic fertilizer on the growth and rhizosphere microorganisms of corn and wheat under drought stress[J]. Journal of Nanjing Agricultural University, 2024, 48(5): 1060-1069. (in Chinese with English abstract) | |
| [24] | MOHAMED A H, ABD EL-MEGEED F H, HASSANEIN N M, et al. Native rhizospheric and endophytic fungi as sustainable sources of plant growth promoting traits to improve wheat growth under low nitrogen input[J]. Journal of Fungi, 2022, 8(2): 94. |
| [25] | MATAR N, MACADRÉ C, AMMAR G A G, et al. Identification of beneficial Lebanese Trichoderma spp. wheat endophytes[J]. Frontiers in Plant Science, 2022, 13: 1017890. |
| [26] | 陆宁海, 杨蕊, 郎剑锋, 等. 小麦根际土壤微生物数量对茎基腐病的影响[J]. 江苏农业科学, 2019, 47(22): 113-116. |
| LU N H, YANG R, LANG J F, et al. Influence of rhizosphere soil microorganisms quantity on wheat crown rot[J]. Jiangsu Agricultural Sciences, 2019, 47(22): 113-116. (in Chinese with English abstract) | |
| [27] | 陈凯, 隋丽娜, 杨凯, 等. 两株木霉共培养发酵提高对小麦苗期茎基腐病的防治效果[J]. 植物病理学报, 2022, 52(3): 425-433. |
| CHEN K, SUI L N, YANG K, et al. Co-culturation of two Trichoderma strains enhanced control efficiency against wheat crown rot at seedling stage[J]. Acta Phytopathologica Sinica, 2022, 52(3): 425-433. (in Chinese with English abstract) | |
| [28] | 扈进冬, 杨在东, 吴远征, 等. 哈茨木霉拌种对冬小麦生长、土传病害及根际真菌群落的影响[J]. 植物保护, 2021, 47(5): 35-40. |
| HU J D, YANG Z D, WU Y Z, et al. Effects of seed dressing treatment with Trichoderma harzianum on the growth of winter wheat seedlings, soil borne diseases and rhizosphere fungal community[J]. Plant Protection, 2021, 47(5): 35-40. (in Chinese with English abstract) | |
| [29] | LIU L, JIN Y Q, LIAN H J, et al. Exploring the biocontrol potential of Phanerochaete chrysosporium against wheat crown rot[J]. Journal of Fungi, 2024, 10(9): 641. |
| [30] | YANG H, CUI S N, WEI Y L, et al. Antagonistic effects of Talaromyces muroii TM28 against Fusarium crown rot of wheat caused by Fusarium pseudograminearum[J]. Frontiers in Microbiology, 2024, 14: 1292885. |
| [31] | ZHAO X L, HOU D Y, XU J Q, et al. Antagonistic activity of fungal strains against Fusarium crown rot[J]. Plants, 2022, 11(3): 255. |
| [32] | 李思敏, 周金彩, 何蓉, 等. 海洋真菌Aspergillus terreus次生代谢产物研究[J]. 天然产物研究与开发, 2023, 35(10): 1732-1738. |
| LI S M, ZHOU J C, HE R, et al. Study on the secondary metabolites from marine-derived fungi Aspergillus terreus[J]. Natural Product Research and Development, 2023, 35(10): 1732-1738. (in Chinese with English abstract) | |
| [33] | 安凡, 姜悦, 王宇, 等. 红树老鼠簕内生真菌Aspergillus terreus GXIMD 03158次级代谢产物研究[J]. 热带海洋学报, 2024, 43(5): 41-48. |
| AN F, JIANG Y, WANG Y, et al. Studies on secondary metabolites of endophytic fungus Aspergillus terreus GXIMD 03158 isolated from mangroves Acanthus ilicifolius L[J]. Journal of Tropical Oceanography, 2024, 43(5): 41-48. (in Chinese with English abstract) | |
| [34] | 王凤婷, 王岩, 孙颖, 等. 耐盐碱土曲霉SYAT-1的分离鉴定及抑制植物病原真菌特性研究[J]. 生物技术通报, 2023, 39(2): 203-210. |
| WANG F T, WANG Y, SUN Y, et al. Isolation and identification of saline-alkali tolerant Aspergillus terreus SYAT-1 and its activities against plant pathogenic fungi[J]. Biotechnology Bulletin, 2023, 39(2): 203-210. (in Chinese with English abstract) | |
| [35] | 纪嵩岩, 邵长琪, 齐文康, 等. 枸杞根腐病病原鉴定及拮抗菌筛选[J]. 浙江农业学报, 2024, 36(10): 2283-2297. |
| JI S Y, SHAO C Q, QI W K, et al. Identification of Lycium barbarum root rot disease pathogens and biocontrol funguses against root rot disease[J]. Acta Agriculturae Zhejiangensis, 2024, 36(10): 2283-2297. (in Chinese with English abstract) | |
| [36] | 王妍, 张福军, 孙卓, 等. 防风枯萎病拮抗真菌的筛选鉴定及防效评价[J]. 华南农业大学学报, 2023, 44(2): 263-269. |
| WANG Y, ZHANG F J, SUN Z, et al. Screening, identification and biological control effect of antagonistic fungus against fusarium wilt of Saposhnikovia divaricata[J]. Journal of South China Agricultural University, 2023, 44(2): 263-269. (in Chinese with English abstract) | |
| [37] | 吕恒, 牛永春, 邓晖, 等. 根际真菌对黄瓜土传病害的抑制作用[J]. 应用生态学报, 2015, 26(12): 3759-3765. |
| LYU H, NIU Y C, DENG H, et al. Suppression of three soil-borne diseases of cucumber by a rhizosphere fungal strain[J]. Chinese Journal of Applied Ecology, 2015, 26(12): 3759-3765. (in Chinese with English abstract) |
| [1] | ZHANG Jun, ZHANG Bo, HU Bibo, LIU Jingliang, ZHANG Xiaoyu, LI Chunyang, XIONG Shengting, GUO Binbin, WANG Xiucun, MA Chao. Identification and expression analysis of members of the SWEET and SUT families in wheat (Triticum aestivum L.) [J]. Acta Agriculturae Zhejiangensis, 2025, 37(9): 1825-1839. |
| [2] | PAN Xinyu, HUANG Huiling, HAN Mingming, SHEN Ningyuan, ZHAO Xudong, LOU Bao. Effects of Cryptocaryon irritans infection on the intestinal histology, immune level and microbiota composition of Larimichthys polyactis [J]. Acta Agriculturae Zhejiangensis, 2025, 37(11): 2265-2274. |
| [3] | LIU Shengnan, ZHU Jianyi, LI Ming, ZHAO Haoyu, XIONG Tao, TANG Yonglu, ZHOU Xiaogang, LI Chaosu. Weed control efficacy and wheat yield in no-tillage rotary sowing after rice stubble [J]. Acta Agriculturae Zhejiangensis, 2025, 37(10): 2129-2137. |
| [4] | HAN Xiao, LIU Xujie, SHI Lyu, ZHANG Jin, SHAN Haiyong, SHI Xiaoxu, YAN Yini, LIU Jian, XUE Yaguang. Effects of reduced application of controlled-release nitrogen fertilizer on rice yield, quality and nitrogen fertilizer utilization efficiency under concentrated coverage of wheat straw between rows for returning to field [J]. Acta Agriculturae Zhejiangensis, 2025, 37(1): 1-13. |
| [5] | YANG Xiaoyu, MA Zhihui, WEI Qing, NIU Zhipeng, CHEN Anqi, HU Zhengchong, WANG Linsheng. Preliminary mapping of a wheat awn length gene and prediction of candidate genes [J]. Acta Agriculturae Zhejiangensis, 2025, 37(1): 14-23. |
| [6] | MIN Jiangyan, TANG Zhuolei, YANG Xue, HUANG Xiaoyan, HUANG Kaifeng, HE Peiyun. Effect of different drought-rewatering modes on growth and yield of Tartary buckwheat [J]. Acta Agriculturae Zhejiangensis, 2024, 36(9): 2000-2009. |
| [7] | SHEN Zhengrong, DAI Yuanxing, GUO Liuming, WANG Zhiyao, ZHANG Hengmu. Preparation and application of specific antibody against coat protein (CP) of Chinese wheat mosaic virus (CWMV) [J]. Acta Agriculturae Zhejiangensis, 2024, 36(9): 2042-2050. |
| [8] | QI Xueli, LI Ying, DUAN Junzhi. Application of salt tolerance genes in wheat salt tolerance genetic engineering [J]. Acta Agriculturae Zhejiangensis, 2024, 36(6): 1447-1457. |
| [9] | LI Jingjing, LI Chuang, LU Yanan, ZHENG Wenming. Identification and expression analysis of Thionin-like gene family in wheat [J]. Acta Agriculturae Zhejiangensis, 2024, 36(4): 729-737. |
| [10] | XUE Xianbin, JIA Qiong, CHEN Zhengfeng, LI Ruiyuan, CHEN Qingfu, SHI Taoxiong. Comprehensive evaluation of agronomic characteristics of recombinant inbred lines of Tartary buckwheat based on principal component analysis [J]. Acta Agriculturae Zhejiangensis, 2024, 36(4): 748-759. |
| [11] | ZHANG Yongbin, LI Xiang, MAN Weidong, LIU Mingyue, FAN Jihao, HU Haoran, SONG Lijie, LIU Weijia. Research on yield estimation method of winter wheat based on Sentinel-1/2 data and machine learning algorithms [J]. Acta Agriculturae Zhejiangensis, 2024, 36(12): 2812-2822. |
| [12] | LIU Yongan, HUANG Yechang, YUE Gaohong, GAO Xiteng, DENG Lizhang, PAN Binrong. Proteomic analysis of grain of high-quality wheat variety Wenmai 10 [J]. Acta Agriculturae Zhejiangensis, 2024, 36(11): 2437-2446. |
| [13] | LOU Yuangen, LI Chuang, LI Jingjing, XING Guozhen, LU Yanan, ZHENG Wenming. Identification and analysis of HP gene family in wheat [J]. Acta Agriculturae Zhejiangensis, 2023, 35(9): 2023-2032. |
| [14] | LI Yanxiang, DING Dedong, HE Jing, ZHANG Jinhua, ZHAO Jitao, ZHAO Qian, HOU Caixia, ZHU Zhu. Antifungal activity and mechanism of wood vinegar against several plant pathogenic fungi [J]. Acta Agriculturae Zhejiangensis, 2023, 35(9): 2149-2159. |
| [15] | WANG Di, YANG Hanmei, LI Yangqian, JIA Mengting, ZOU Liang, YANG Fan. Multidimensional evaluation of “variety, quality, efficiency and application” of Tartary buckwheat and research progress of high-value utilization of active ingredients [J]. Acta Agriculturae Zhejiangensis, 2023, 35(8): 1960-1974. |
| Viewed | ||||||
|
Full text |
|
|||||
|
Abstract |
|
|||||




